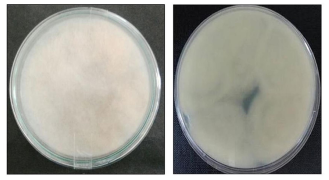

1. INTRODUCTION
A number of industrially important hydrolysing enzymes have been reported from various microbial sources. Inulinases are one of these important enzymes which act on β, 2-1 linkages of inulin to produce various industrial products. Inulinases have been grouped into two glycoside hydrolase (GH) families, i.e. 32 and 91, on the basis of their action on inulin to produce fructose/fructooligosaccharides or difructose anhydrides, respectively. Amongst various inulin-acting enzymes, exoinulinase (EC 3.2.1.80), endoinulinase (EC 3.2.1.7), 1-exohydrolase (EC 3.2.1.153), 1, 2-β-fructan 1F-fructosyltransferase (EC 2.4.1.100) and sucrose 1F-fructosyltransferase (EC 2.4.1.99) are members of GH 32 family, whereas fructotransferases also known as inulin lyases (EC 4.2.2.17 and 4.2.2.18) are a member of GH 91. Inulinases acts differently on β, 2-1 linkages of inulin. Hence, according to their action pattern on inulin, they are categorised as: exoinulinase (EC 3.2.1.80) and endoinulinase (3.2.1.7). Exoinulinase sequentially breaks inulin, whereas endoinulinase randomly breaks internal linkages of the polymer to produce fructooligosaccharides of varied chain length [1]. Bacteria, yeast and flamentous fungi are the microbial sources of inulinases. However, the use of fungal sources has increased tremendously due to their high thermal stability, presence of synergistic effect between enzymes to produce important industrial products and wide pH stability. Aspergillus sp., Penicillium sp., Chrysosporium sp., Rhizopus sp., etc. are some potent fungal inulinase producers [1]. Various low-cost substrates like root tubers of Asparagus sp. [2-4], raw dahlia inulin [5], carrot pomace [6] have been used for inulinase production. The production of high fructose syrup [7-12] and fructooligosaccharides [13, 14] are the two major applications of inulinases. Additionally, inulinases have also been used for the production of other important industrial products like citric acid, lactic acid, bioethanol, single cell oil, single cell proteins, etc. [15, 16].
The formulation of medium for a fermentation process is a very important aspect to obtain optimal microbial growth and enhanced metabolite production. The conventional method of optimization i.e., changing one independent variable at-a-time, while fixing the other variables at a certain level, is a single-dimensional search method. It is a simple technique and allows understanding the role played by every single factor. Therefore, this approach was used for the formulation of medium for inulinase production from Mucor circinelloides BGPUP-9 in shake-flask fermentations. This is the first report on inulinase production from this microorganism.
2. MATERIALS AND METHODS
2.1. Fungal Culture
An inulinase producing fungal isolate BGPUP-9 was isolated from inulin-rich root tubers of Asparagus racemosus by the method as described previously [17]. The culture was maintained on potato dextrose agar (PDA; HiMedia Laboratories, Mumbai, India) slants and stored at 4°C, until further use.
2.2. Phenotypic Characterization of Fungal Isolate BGPUP-9
2.2.1. Macromorphology
Macromorphological characteristics of fungal isolate BGPUP-9 was investigated according to fungal monograph [18]. Fungal isolate BGPUP-9 was grown on malt extract peptone dextrose agar (MEA; HiMedia Laboratories, Mumbai, India) at 30°C for 7 days to study its colonial characteristics. Colony features such as obverse-reverse colony color, growth and change in colony color with time, and mycelial height were examined.
2.2.2. Micromorphology
Micromorphological characteristics like sporangiophores shape and size, columellae size and appearance, chlamydospore formation, sporangiospores shape, and size, etc. were also studied. Microscopic slides of fresh and active culture were prepared using lactophenol cotton blue dye. Photomicrographs of fungal isolate BGPUP-9 were obtained using Leica DM 4000 B LED microscope fitted with a digital camera DFC450C (Germany). Fungal isolate BGPUP-9 was identified up to generic level by following fungal monograph [18].
2.3. Molecular Identification
2.3.1. DNA extraction
Genomic DNA of fungal isolate BGPUP-9 was isolated according to fungi genomic DNA isolation kit (Bangalore, Genei Private Ltd., India). The isolated DNA was quantified by taking its absorbance at 260 and 280 nm, using the convention that one absorbance unit at 260 nm stands for 50 μg DNA per mL. The optical density ratio 260:280 nm was employed for DNA purity check. DNA ratio between 1.8 and 2.0 was considered as a purified product. Later on, quality of the DNA preparation was checked by running it in 0.8% agarose gel containing ethidium bromide (0.5 μg/mL) at 80 V for 30 min, using a horizontal electrophoretic unit (Axygen, USA). Later on, bands were visualized under a UV transilluminator (BioRad, USA).
2.3.2. 18S rRNA gene sequencing
18S rRNA gene was amplified by polymerase chain reaction (PCR) using fungal universal primers provided by Yaazh Xenomics (Tamil Nadu, India). A total volume of 25 μL of amplification reaction mixture containing 2.0 μL DNA (30 ng/μL), mixture of 2.0 μL of deoxynucleoside triphosphates (dNTPs 200 μm/μL), 2.5 μL of 10x Taq buffer A containing 50 mM MgCl2, 1 μL of each forward and reverse oligonucleotide primer (10 ppm/μL), 0.5 μL of Taq DNA polymerase (3 U/μL) and rest nuclease-free water was added to make up the final volume. Amplification was carried out using a thermocycler (Master Cycler Personal, Eppendorf AG, Germany). The thermal amplification conditions included initial denaturation at 94°C for 5 min followed by 35 cycles of denaturation at 94°C for 45 s, annealing at 55°C for 60 s and an extension at 72°C for 90 s with a final extension at 72°C for 10 min. The amplified PCR product was run in 1.0% agarose gel and visualized on a UV transilluminator (BioRad, USA). The PCR product was further purified using a gel extraction kit (Sigma, USA). Afterward, bidirectional sequencing of the purified PCR product was carried out using 16 capillaries automated ABI 3730xl genetic analyzer (Applied Biosystems, USA). The 18S rRNA gene sequence of 709 bp was obtained. The homology of the DNA sequence was determined using BLAST against NCBI nucleotide database [19].
2.3.3. Phylogenetic analysis
The 18S rRNA gene sequence data were aligned using BLAST preview against the reference nucleotide sequences. The retrieved nucleotide sequences from GenBank were used to find the closest homolog of fungal isolate BGPUP-9 employing Clustal W program [20, 21]. Kimura-2 parameters based on nucleotide sequence homology was used to compute the distance matrix [22], whereas phylogenetic tree was constructed by neighbor-joining method [23] using MEGA 6 software [24]. For the accurate representation of the evolutionary history of fungal isolate BGPUP-9, a bootstrap consensus tree was generated using 1000 replicates [25].
2.4. Inoculum Preparation
The inoculum was prepared by inoculating fungal stock culture onto PDA plates. Agar plates were incubated at 30°C for 5 days. One agar disc (10 mm), uniformly covered with mycelia was used as inoculum for inulinase production in shake-flask fermentations.
2.5. Inulinase Production from Mucor circinelloides BGPUP-9 under Stationary and Agitation Mode of Cultivation
A relative study on inulinase production under stationary and agitation mode of cultivation was carried out at flask-level. Erlenmeyer flasks (250 mL) containing 50 mL production medium (%, w/v): inulin 2, NaNO3 0.2, NH4H2PO4 0.2, KH2PO4 0.2, KCl 0.1, MgSO4.7H2O 0.05, FeSO4.7H2O 0.001 and adjusted to pH 6.0, was inoculated with one mycelial agar disc (10 mm) of 5 days old fungal culture. Thereafter, flasks were individually incubated under stationary and agitation (150 rpm) mode at 30°C for 5 days.2.6. Inulinase Production from M. circinelloides BGPUP-9 with Time-Course as a Function
Inulinase production by M. circinelloides BGPUP-9 was studied in shake-flask fermentations as a function of time. One fungal mycelial agar disc (10 mm) of 5 days old culture was inoculated into pre-sterilized fermentation medium (composition same as described in section 2.5). The inoculated flasks were incubated for 7 days at 30°C, under agitation (150 rpm) on a rotary shaker (CIS-24 BL, REMI, Mumbai, India). The samples were withdrawn after 24 h of time interval, to determine inulinase production.
2.7. Formulation of Medium for Inulinase Production from M. circinelloides BGPUP-9
2.7.1. Screening of carbon sources
The effect of different carbon sources viz., inulin, sucrose, lactose, fructose, glucose, starch and maltose (2%) in combination with inulin (0.5%, as an inducer) was observed on inulinase production from M. circinelloides BGPUP-9 at shake-flask level. Each carbon source was added individually into Erlenmeyer flasks (250 mL) containing 50 mL production medium containing (%, w/v): NaNO3 0.2, NH4H2PO4 0.2, KH2PO4 0.2, KCl 0.1, MgSO4.7H2O 0.05, FeSO4.7H2O 0.001 and pH adjusted to 6.0. One fungal mycelial agar disc (10 mm) was used as inoculum and the inoculated flasks were incubated at 30°C for 4 days, under agitation (150 rpm).
2.7.2. Effect of inulin concentration
To determine the optimal concentration of inulin for inulinase production, its different concentrations (0.5-3%, w/v) were supplemented individually in Erlenmeyer’s flasks containing pre-sterilized fermentation medium (mentioned in section 2.7.1). Flasks inoculated with one mycelial agar disc (10 mm) of 5 days old fungal culture were incubated at 30°C for 4 days, under agitation (150 rpm).
2.7.3. Screening of nitrogen sources
The effect of various nitrogen sources namely, ammonium dihydrogen orthophosphate, di-ammonium hydrogen orthophosphate, sodium nitrate, ammonium sulfate, ammonium chloride, peptone and yeast extract on inulinase production was also investigated in shake-flask fermentations. Each flask containing the production medium was individually supplemented with each nitrogen source (0.5%). Thereafter, flasks were inoculated with one fungal mycelial agar disc (10 mm) and incubated at 30°C for 4 days, under agitation (150 rpm).
2.7.4. Effect of concentration of ammonium dihydrogen orthophosphate
Different concentrations (0.5-3.0%, w/v) of ammonium dihydrogen orthophosphate were added individually in different flasks containing the same fermentation medium (mentioned in section 2.7.3). Afterward, each flask was inoculated with one fungal mycelial disc of 5 days old culture and incubated at 30°C for 4 days, under agitation (150 rpm).
2.7.5. Effect of concentration of potassium dihydrogen orthophosphate and potassium chloride
The effect of different concentrations (0.1-0.5%, w/v) of potassium dihydrogen orthophosphate and potassium chloride on inulinase production from M. circinelloides BGPUP-9 was also examined.
2.7.6. Effect of production medium pH
Medium pH also has a significant effect on enzyme production. To examine its effect on inulinase production from M. circinelloides BGPUP-9, flasks containing pre-sterilized production medium (mentioned in section 2.7.5) were adjusted to different pH range (5.0-8.0). After inoculation, shake-flask fermentations were carried out on a rotary shaker at 30°C for 4 days, under agitation (150 rpm).
2.8. Thin Layer Chromatography
The action pattern of inulinase from M. circinelloides BGPUP-9 was determined using thin layer chromatography (TLC) as described by Singh et al. [17].
2.9. Analytical Techniques
2.9.1. Inulinase and invertase assay
Inulinase and invertase were assayed for their activities by measuring the concentration of reducing sugars in inulin and sucrose hydrolysates, respectively. The reaction mixtures comprising 100 μL of crude enzyme and 2% of inulin/sucrose solution (prepared in 0.1 M sodium acetate buffer, pH 5.0) were incubated at 55°C. After incubation of 10 min, the reaction was terminated by boiling reaction mixture for 15 min, then aliquots of 100 μL were withdrawn and assessed for reducing sugars by 3,5 dinitrosalicylic acid method [26]. One inulinase unit is the amount of enzyme which releases 1 μmol of fructose per min, whereas one invertase unit is the amount of enzyme which hydrolyses 1 μmol of sucrose per min, under standard assay conditions.
2.9.2. I/S ratio
The ratio between inulinase and invertase activities is generally expressed as I/S ratio. I/S ratio is used to determine the nature of enzyme. High I/S ratio indicates the specificity of the enzyme for inulin only, which further justifies the inulinase nature of the enzyme.
3. RESULTS AND DISCUSSION
3.1. Isolation of Inulinase Producing Fungal Strain
An inulinase producing fungal strain BGPUP-9 was isolated from inulin-rich root tubers of Asparagus racemosus. Fungal isolate BGPUP-9 showed an adequate inulinase production (5.55 IU/mL) and very low invertase activity (0.076 IU/mL). The corresponding I/S ratio was also very high (72.86). Generally, enzyme activity on inulin versus sucrose is used for the characterization of inulinase. I/S ratio greater than 10-2 specifies inulinase nature, whereas ratio lower than 10-4 characterizes enzyme as invertase [27]. High I/S ratio of fungal isolate BGPUP-9 indicates the specificity of the enzyme active site for inulin only. Other fungal inulinase producers such as Penicillium oxalicum [17], Aspergillus niger [28] and Rhizopus microsporus [29] also corroborates our findings.
3.2. Phenotypic Characterization of Fungal Isolate BGPUP-9
Morphological identification of the isolated strain revealed its various distinctive micro- and macroscopic features.
3.2.1. Macromorphology
The colonies of fungal isolate BGPUP-9 on MEA were fast growing, which covered whole agar plate in 3-5 days of cultivation. Moreover, colonies were 10-15 mm high forming a turf olivaceous-buf. The obverse of the agar plate was light to dark brown, while reverse was pale brown to apricot in color (Fig. 1). Growth of fungal strain on MEA medium is an important feature for its identification, because different strains shows varied pattern of growth on the same medium.
| Figure 1: Obverse and reverse view of Mucor circinelloides BGPUP-9 on malt extract peptone dextrose agar (MEA) at 30°C. [Click here to view] |
3.2.3. Micromorphology
Fungal isolate BGPUP-9 also possessed some unique and differentiated microscopic characteristics (Fig. 2). Sporangiophores were erect and rarely circinate, tall, ellipsoidal, hyaline, 6.5-9 × 3.5-5 μm in size, which repeatedly differentiated into sympodial short and larger branches. Short sporangiophores branched heavily, often circinate, appeared white at early stage, while turned dark brown with age. Sporangium was globose in shape at the edge of the sporangiophore and its wall was incrusted, hyaline and fragile. Larger ones were deliquescent, 45-60 μm in diameter and having globose to oval columellae at the apex. Columellae were generally hyaline and 10-25 × 10-15 μm in size. Sporangiospores were ellipsoidal in shape. Chlamydospores were formed on the substratum at the later stage of cycle due to depletion of nutrients or other adverse conditions. Chlamydospores were single and in chains and 5-8 × 3.3 μm in size. According to micro-morphological investigations based on mycological monograph [8], isolate BGPUP-9 was identified as Mucor sp.
 | Figure 2: Overview of microscopic features of Mucor circinelloides, BGPUP-9 (a): Ellipsoidal sporangiospores; (b): Globose sporangium at the edge of sporangio-phore; (c): Bursting of sporangia to release sporangiospores; (d): Chlamydospores at later stage of growth; (e): Sporangiophore with chlamydospores in chain. [Click here to view] |
18S rRNA gene sequencing was performed to commend species-specific identification of fungal isolate BGPUP-9. A sequence of 709 bp was obtained after 18S rRNA gene amplification and sequencing. The sequenced data were submitted to GenBank which has been assigned accession number MF461643. On the basis of nucleotide homology and alignment of a nucleotide sequence with retrieved data, fungal isolate BGPUP-9 showed high similarity with Mucor circinelloides. Hence, the isolate was identified as Mucor circinelloides and named as Mucor circinelloides BGPUP-9.
3.4. Phylogenetic Analysis
Phylogenetic analysis of 18S rRNA gene was performed on the basis of nucleotide homology. The evolutionary history was obtained using neighbor-joining method [23]. The evolutionary distances were computed using Kimura-2 parameter method [22], and are in the units of the number of base substitutions per site. The percentage of replicate trees in which the associated taxa clustered together in the bootstrap test (1000 replicates) are shown next to the branches [25]. On the basis of the morphological study, 18S rRNA gene sequencing and phylogenetic examination, the identification of fungal isolate BGPUP-9 was confirmed as Mucor circinelloides (Fig. 3). Mucor racemosus (JQ683250) was found its closest homolog.
 | Figure 3: Phylogenetic tree based on neighbor joining method showing relationship among 18S rRNA gene sequence of Mucor circinelloides BGPUP-9 and other close homologs. The evolutionary distances were computed using Ki-mura-2 parameter method. [Click here to view] |
3.5. Inulinase Production from M. circinelloides BGPUP-9 under Stationary and Agitation Mode of Cultivation
A significant increase in inulinase production (9.10 IU/mL) was observed under agitation in comparison to stationary mode (5.55 IU/ mL), after 5 days of cultivation (Fig. 4). Agitation is important to maintain culture uniformity in the medium. It also contributes to the proper dissipation of oxygen and nutrient in the medium to actively growing culture, which subsequently enhances metabolite production. Thus, proper oxygen dissipation and nutrient availability to the growing fungal culture can be attributed for an enhanced inulinase production in shake-flask fermentations. Other fungal sources such as Penicillium oxalicum [17], P. subrubescens [30], A. niger [31], etc. have also been reported high inulinase producers under agitation mode of cultivation. | Figure 4: Inulinase production from M. circinelloides BGPUP-9 under stationary and agitation mode of cultivation. [Click here to view] |
3.6. Inulinase Production from M. circinelloides BGPUP-9 with Time-Course as a Function
The maximum inulinase production (11.49 IU/mL) from M. circinelloides BGPUP-9 was obtained after 4 days of shake-flask fermentation. Thereafter, a continuous decline in inulinase production was observed (Fig. 5), which may be attributed to the secretion of proteases into the media which denatured the enzyme by hydrolyzing its peptide bonds between amino acids. A relative comparison of inulinase production from other fungal sources like P. spinulosum (1.60 IU/mL) and Trichoderma viride (0.94 IU/mL) [32], P. expansum (2.99 IU/mL) [33], Zygosaccharomyces bailii (8.67 IU/mL) [34], etc. shows M. circinelloides BGPUP-9 as a potent inulinase producer.
 | Figure 5: Inulinase production from M. circinelloides BGPUP-9 as a function of time. [Click here to view] |
3.7. Effect of Carbon Sources on Inulinase Production from M. circinelloides BGPUP-9
The effect of different carbon sources in combination with inulin (as an inducer) on inulinase production was also determined. The maximum inulinase production (11.51 IU/mL) was observed from inulin as a sole carbon source as well as an inducer. The corresponding I/S ratio was also high (37.52). The order of inulinase production from various carbon sources was inulin > sucrose > lactose > maltose > glucose > fructose > starch (Fig. 6). Inulin acts as an inducer as well as a carbon source for inulinase synthesis. Its small amount supplemented in the production medium easily triggers inulinase biosynthesis. Our results are in accordance with the findings on inulinase production from P. oxalicum [17], Cryptococcus aureus [35] and Kluyveromyces marxianus [36].
 | Figure 6: Effect of different carbon sources on inulinase production from M. circinelloides BGPUP-9. [Click here to view] |
3.8. Effect of Inulin Concentration on Inulinase Production from M. circinelloides BGPUP-9
An increase in inulinase production with an increase in inulin concentration up to 2.5% was observed. Thereafter, a decline in inulinase production was recorded (Fig. 7). The maximum inulinase production obtained at 2.5% inulin concentration was 19.14 (IU/mL). The reduction in inulinase production at higher inulin concentration can be ascribed to catabolite repression occurred due to excessive free reducing sugars accumulation. The signals produced by the accumulated sugars repress the expression of certain genes, which further alters and effects enzyme conformation and activity. A similar pattern of inulinase production has been reported from P. oxalicum [17], K. marxianus [36], A. ficuum [37] and A. niger [38].
 | Figure 7: Effect of concentration of inulin on inulinase production from M. circinelloides BGPUP-9. [Click here to view] |
3.9. Effect of Nitrogen Sources on Inulinase Production from M. circinelloides BGPUP-9
Nitrogen is one of the very important components for enzyme synthesis. Nitrogen molecule is an integral part of amino acids, which are further responsible for the significant variation in conformation of different proteins. Effect of nitrogen source on metabolite production solely depends upon the microbial source. Additionally, the synergistic effect of nitrogen source with other medium constituents also has a profound effect on metabolite production. In the present study, the maximum inulinase production (19.20 IU/mL) was obtained from inorganic nitrogen source (NH4H2PO4), whereas peptone (an organic source) supported the least inulinase production. The order of inulinase production from various nitrogen sources was NH4H2PO4 > NaNO3 > NH4Cl > yeast extract > (NH4)2SO4 > (NH4)2HPO4 > peptone (Fig. 8). Our findings are in agreement with the results of inulinase production from Bacillus sp. [39], B. safensis [40], A. ficuum [37] and A. tritici [41], where inorganic nitrogen sources supported maximum inulinase production.
 | Figure 8: Effect of different nitrogen sources on inulinase production from M. circinelloides BGPUP-9. [Click here to view] |
3.10. Effect of Concentration of Ammonium Dihydrogen Orthophosphate
An increase in inulinase production (23.56 IU/mL) up to 3.0% of ammonium dihydrogen orthophosphate was observed. Afterwards, a reduction in inulinase production was pragmatic. The higher concentration of NH4H2PO4 was found inhibitory for inulinase synthesis from M. circinelloides BGPUP-9 (Fig. 9). A decline in inulinase production at higher concentration of peptone has been reported from A. niger [42] and P. funiculosum [43]. The stunted growth of K. marxianus and low inulinase production at higher concentration of meat extract has also been reported [36].
 | Figure 9: Effect of concentration of NH4H2PO4 on inulinase production from M. circinelloides BGPUP-9. [Click here to view] |
3.11. Effect of Concentration of Potassium Dihydrogen Orthophosphate and Potassium Chloride
At optimal concentration of 0.2% of potassium dihydrogen orthophosphate and 0.1% of potassium chloride, the maximum inulinase production obtained was 23.45 IU/mL and 23.59 IU/mL, respectively (Fig. 10 and 11). Thereafter, a reduction in inulinase production was observed in both the cases. Higher concentration of both the medium supplements was inhibitory for inulinase production. Potassium dihydrogen orthophosphate and potassium chloride are basic components of the medium used for both microbial growth and inulinase production from various microorganisms [6, 16, 44]. The presence of these components in the medium has been reported to have a synergistic effect with other components for inulinase production. Zherebtsov et al. [45] supplemented both the components in the production medium for inulinase production from Bacillus sp. A. niger has also been reported to produce maximum inulinase production in a medium supplemented with KH2PO4 [31].
 | Figure 10: Effect of concentration of KH2PO4 on inulinase production from M. circinelloides BGPUP-9. [Click here to view] |
 | Figure 11: Effect of different concentration of KC1 on inulinase production from M. circinelloides BGPUP-9. [Click here to view] |
3.12. Effect of Production Medium pH on Inulinase Production from M. circinelloides BGPUP-9
The maximum inulinase production (23.55 IU/mL) was observed at pH 6.0 from M. circinelloides BGPUP-9. Thereafter, a decline in inulinase production was observed (Fig. 12). Fungal sources have been reported to have good hyphal growth in slightly acidic environment, which consequently contributes to the more enzyme yield [1]. Medium pH solely affects cell metabolism rate as well as surface charge distribution of the enzyme. Hence, a slight change can inhibit or stimulate enzyme production. Our results are in accordance with the findings on inulinase production from K. marxianus [36] and A. tritici [41].
 | Figure 12: Effect of production medium pH on inulinase production from M. circinelloides BGPUP-9. [Click here to view] |
3.13. Thin Layer Chromatography
Thin layer chromtography evidenced the exoinulolytic nature of the enzyme from M. circinelloides BGPUP-9 (Fig. 13). The developed TLC plate revealed the liberation of fructose as main end product after inulinase hydrolytic action on inulin.
 | Figure 13: Thin layer chromatogram of hydrolysate formed after catalytic action of inulinase from M. circinelloides BGPUP-9 on inulin, Lane 1-3: Glucose, fructose, and sucrose standards; Lane 4: Inulin hydrolysate. [Click here to view] |
4. CONCLUSION
Morphological characterization of fungal isolate BGPUP-9 identified it as Mucor sp. Molecular characterization and phylogenetic analysis have further revealed it as Mucor circinelloides. Agitation mode of cultivation shown a significant increase in inulinase production in shake-flask fermentations. The optimized formulation medium showed an imperative 3.3-fold increase in inulinase production from Mucor circinelloides BGPUP-9 in shake-flask fermentations. The present study revealed M. circinelloides BGPUP-9 as a potent candidate for inulinase production. The experimentation carried out in shake-flask fermentations for the production of inulinase from M. circinelloides BGPUP-9 will provide very useful guidelines for scale-up studies.
5. ACKNOWLEDGMENT
Authors are thankful to Head, Department of Biotechnology, Punjabi University, Patiala for providing necessary laboratory facilities to execute this work.
6. REFERENCES
1. Singh RS, Chauhan K. Production, purification, characterization and applications of fungal inulinases. Current Biotechnology 2018; 7:242-260. Crossref
2. Singh RS, Bhermi HK. Production of extracellular exoinulinase from Kluyveromyces marxianus YS-1 using root tubers of Asparagus officinalis. Bioresource Technology 2008; 99:7418-7423. Crossref
3. Singh RS, Dhaliwal R, Puri M. Production of inulinase from Kluyveromyces marxianus YS-1 using root extract of Asparagus racemosus. Process Biochemistry 2006; 41:1703-1707. Crossref
4. Singh RS, Singh RP. Response surface optimization of endoinulinase production from a cost effective substrate by Bacillus safensis AS-08 for hydrolysis of inulin. Biocatalysis and Agricultural Biotechnology 2014; 3:365-372. Crossref
5. Singh RS, Saini GK. Production of inulinase from raw dahlia inulin by Kluyveromyces marxianus YS-1. Journal of Scientific and Industrial Research 2013; 72:603-610.
6. Singh RS, Chauhan K, Singh J, Pandey A, Larroche C. Solid state fermentation of carrot pomace for the production of inulinase from Penicillium oxalicum BGPUP-4. Food Technology and Biotechnology 2018; 56:31-39. Crossref
7. Singh RS, Chauhan K, Singh RP. 2017. Enzymatic approaches for the synthesis of high fructose syrup. In: Gahlawat SK, Salar RK, Siwach P, Duhan JS, Kumar S, Kaur P, editors. Plant Biotechnology: recent advancements and developments, Singapore: Springer Nature Singapore Pte Ltd. 189-211. Crossref
8. Singh RS. 2011. Enzymatic preparation of high fructose syrup from inulin. In: Sharma PS, Sharma HK, Sarkar BC, editors. Bioprocessing of foods. New Delhi, India: Asiatech Publishing Inc 77-98.
9. Singh RS, Dhaliwal R, Puri M. Production of high fructose syrup from Asparagus inulin using immobilized exoinulinase from Kluyveromyces marxianus YS-1. Journal of Industrial Microbiology and Biotechnology 2007; 34:649-655. Crossref
10. Singh RS, Dhaliwal R, Puri M. Partial purification and characterization of exoinulinase from Kluyveromyces marxianus YS-1 for preparation of high fructose syrup. Journal of Microbiology and Biotechnology 2007; 17:733-738.
11. Singh RS, Dhaliwal R, Puri M. Development of a stable continuous flow immobilized enzyme reactor for the hydrolysis of inulin. Journal of Industrial Microbiology and Biotechnology 2008; 35:777-782. Crossref
12. Singh RS, Singh RP, Kennedy JF. Immobilization of yeast inulinase on chitosan beads for the hydrolysis of inulin in a batch system. International Journal of Biological Macromolecules 2017; 95:87-93. Crossref
13. Singh RS, Singh RP. Production of fructooligosaccharides from inulin by endoinulinases and their prebiotic potential. Food Technology and Biotechnology 2010; 48:435-450.
14. Singh RS, Singh RP, Keneddy JF. Recent insights in the enzymatic synthesis of fructooligosaccharides from inulin. International Journal of Biological Macrmolecules 2016; 85:565-572. Crossref
15. Chi ZM, Zhang T, Cao T-S, Liu X-Y, Cui W, Zhao C-H. Biotechnological potential of inulin for bioprocesses. Bioresource Technology 2011; 102:4295-4303. Crossref
16. Singh RS, Chauhan K, Kennedy JF. A panorama of bacterial inulinases: production, purification, characterization and industrial applications. Interantional Journal of Biological Macrmolecules 2017; 96:312-322. Crossref
17. Singh RS, Chauhan K. Inulinase production from a new inulinase producer, Penicillium oxalicum BGPUP-4. Biocatalysis and Agricultural Biotechnology 2017; 9:1-10. Crossref
18. Nagamani A, Kunwar IK, Manoharachary C. 2005. Composition of different media, description of fungi. In: Nagamani A, Kunwar IK, editors. Handbook of Soil Fungi, I.K. New Delhi, India: International Pvt. Ltd. 296-305.
19. Altschul SF, Gish W, Miller W, Myers EW, Lipman, DJ. Basic local alignment search tool. Journal of Molecular Biology 1990; 215:403-410. Crossref
20. Benson DA, Cavanaugh M, Clark K, Karsch-Mizrachi I, Lipman DJ, Ostell J, Sayers EW. GenBank. Nucleic Acids Research 2013; 41 (Database issue), D36-D42.
21. Thompson JD, Higgins DG, Gibson TJ. CLUSTAL W: improving the sensitivity of progressive multiple sequence alignment through sequence weighting, position-specific gap penalties and weight matrix choice. Nucleic Acids Research 1994; 22:4673-4680. Crossref
22. Kimura M. A simple method for estimating evolutionary rates of base substitutions through comparative studies of nucleotide sequences. Journal of Molecular Evolution 1980; 16:111-120. Crossref
23. Saitou N, Nei M. The neighbor-joining method: a new method for reconstructing phylogenetic trees. Molecular Biology and Evolution 1987; 4:406-425.
24. Tamura K, Stecher G, Peterson D, Filipski A, Kumar S. MEGA 6: molecular evolutionary genetics analysis version 6.0. Molecular Biology and Evolution 2013; 30:2725-2729. Crossref
25. Felsentein J. Confidence limits on phlyogenies: an approach using the bootstrap. Evolution 1985; 39:783-791. Crossref
26. Miller GL. Use of dinitrosalicyclic acid reagent for determination of reducing sugars. Analytical Chemistry 1959; 31:426-428. Crossref
27. Ettalibi M, Baratti JC. Purification, properties and comparison of invertase, exoinulinases and endoinulinases of Aspergillus ficuum. Applied Microbiology Biotechnology 1987; 26:13-20. Crossref
28. Kango N. Production of inulinase using tap roots of dandelion (Taraxacum offcinale) by Aspergillus niger. Journal of Food Engineering 2008; 85:473-478. Crossref
29. Flores-Gallegos AC, Contreras-Esquivel JC, Morlett-Chávez JA, Aguilar CN, Rodríguez-Herrera R. Comparative study of fungal strains for thermostable inulinase production. Journal of Bioscience and Bioengineering 2015; 119:421-426. Crossref
30. Mansouri S, Houbraken J, Samson RA, Frisvad JC, Christensen M, Tuthill DE, Koutaniemi S, Hatakka A, Lankinen P. Penicillium subrubescens, a new species effciently producing inulinase. Antonie Van Leeuwenhoek 2013; 103:1343-1357. Crossref
31. Kumar GP, Kunamneni A, Prabhakar T, Ellaiah P. Optimization of process parameters for the production of inulinase from a newly isolated Aspergillus niger AUP19. World Journal of Microbiology and Biotechnology 2005; 21:1359-1361. Crossref
32. Ertan F, Ekinci F, Aktac T. Production of inulinases from Penicillium spinulosum, Aspergillus parasiticus NRRL 2999 and Trichoderma viride. Pakistan Journal of Biological Sciences 2003; 6:1332-1335. Crossref
33. Fernandes MRVS, Nsabimana C, Jiang B. Penicillium expansum SK16 as a novel inulinase-producing strain isolated from decomposed dahlia tubers. Research Journal of Biotechnology 2012; 7:102-106.
34. Paixão SM, Teixeira PD, Silva TP, Teixeira AV, Alves L. Screening of novel yeast inulinases and further application of bioprocesses. New Biotechnology 2013; 30:598-606. Crossref
35. Sheng J, Chi Z, Li J, Gao L, Gong F. Inulinase production by the marine yeast Cryptococcus aureus G7a and inulin hydrolysis by the crude inulinase. Process Biochemistry 2007; 42:805-811. Crossref
36. Singh RS, Sooch BS, Puri M. Optimisation of medium and process parameters for the production of inulinase from a newly isolated Kluyveromyces marxianus YS-1. Bioresource Technology 2007; 98:2518-2525. Crossref
37. Jing W, Zhengyu J, Bo J, Augustine A. Production and separation of exo- and endoinulinase from Aspergillus ficuum. Process Biochemistry 2003; 39:5-11. Crossref
38. Rawat HK, Soni H, Kango N, Kumar CG. Continuous generation of fructose from Taraxacum offcinale tap root extract and inulin by immobilised inulinase in a packed-bed reactor. Biocatalysis and Agricultural Biotechnology 2017; 9:134-140. Crossref
39. Gavrailov S, Ivanova V. 2016. Effects of nitrogen and carbon sources on the production of inulinase from strain Bacillus sp. SG113. Acta Scientifica Naturalis 2016; 3:68-73. Crossref
40. Singh RS, Singh RP, Yadav M. Molecular and biochemical characterization of a new endoinulinase producing bacterial strain of Bacillus safensis AS-08. Biologia 2013; 68:1028-1033. Crossref
41. Singh RS, Singh RP, Kennedy JF. Endoinulinase production by a new endoinulinase producer Aspergillus tritici BGPUP6 using a low cost substrate. Interantional Journal of Biological Macromolecules 2016; 92:1113-1122. Crossref
42. Al-Dabbagh YN, Mahmood WA. Effect of carbon, nitrogen and pH on inulinase production from local isolate of Aspergillus niger. Zanco Journal of Pure Applied Sciences 2015; 27:1-8.
43. Danial EN, Al-Bishri WKW. New isolate for enhancement production of microbial inulinase. Bioscience. Journal Uberlândia 2015; 31:1550-1560.
44. Singh RS, Singh RP. 2017. Inulinases. In: Pandey A, Negi S, Soccol CR, editors. Current Developments in Biotechnology and Bioengineering. Cambridge, US: Elsevier Inc 423-446. Crossref
45. Zherebtsov NA, Shelamova SA, Abramova IN. Biosynthesis of inulinases by Bacillus bacteria. Applied Biochemistry and Microbiology 2002; 38:544-548. Crossref